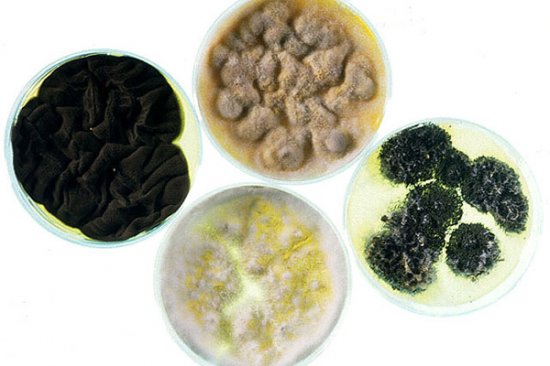
Откриха гъба, синтезираща нафта

Откриха ценно “Бугати”, прашасало в гараж
Класически автомобил “Бугати” – мечтата на колекционерите, почти половин век събирал прах в гараж на британец. Авто - Type 57S Atalante, производство 1937 г., е бил открит в гаража на доктор Харолд Кар, бивш военен хирург от Нюкасъл, предаде Би Би Си.
Показаха компютърни изображения Lotec Sirius
Моделът е конкурент на Bugatti Veyron и Koenigsegg CCX-R, но ще има едва по няколко бройки на година.
Най-бързото Lambo, правено някога
Edo competition представи ограничено издание Lamborghini LP 710, което според тях ще е най-бързото Lambo, правено досега.
Hyundai разработва автомобил за 5 000 долара
Hyundai Motor Co работи по сглобяването на малък автомобил на цена между 5 000 и 6 000 долара специално за пазарите на Китай и Индия.
Maserati с още по-спортна версия на Quattroporte
На автосалона в Детройт Maserati ще представи версията Sport GT S на четиривратия си модел Quattroporte с още по-спортни настройки и по-динамични показатели.
Най-„замърсяващите” автомобили
Съставен е рейтинг на най-„замърсяващите” автомобили в света, които изхвърлят в атмосферата най-голямо количество вредни вещества. Спортните коли и лимузините са първи в този списък.
Отвориха Южната дъга на Околовръстното
Премиерът Сергей Станишев, директорът на Национална агенция „Пътна инфраструктура” Янко Янков и кметът на София Бойко Борисов ще открият Южната дъга на софийския околовръстен път при пътен възел „Симеоново“.
„Автомобил на годината в US” - номинации
Американско жури избра претендентите за приза „Автомобил на годината в Северна Америка”. Този път местните и чуждестранни автопроизводители са представени по равно – три американски, два немски и един „кореец”.
Уникален KTM X-Bow участва в родно “Шампионско шоу”
Благотворително състезание, подобно на Race of Champions, се проведе на 21.12.2008 г. на летището край Сапарева баня. Приходите от състезанието отиват за дом за деца в с. Горна Козница
Откритият Mercedes-Benz SLR се казва Stirling Moss
Официална информация ще бъде разпространена по време на салона в Детройт.
Aston Martin Rapide с дебют в Женева
Aston Martin показа първи снимки на серийния модел Rapide, чиято официална премиера се очаква на автосалона в Женева през март следващата година.
volvo
Volvo показа следващото S60
Буквално дни преди Коледа Volvo Cars показа как ще изглежда бъдещият S60, чиято серийна версия ще запрепуска по улиците от 2010 г.
chrysler
Chrysler спира цялото си производство
Автомобилният гигант Chrysler обяви, че прекратява производството за поне месец, докато стане известно дали ще бъде отпусната финансовата помощ от американското правителство.
Откриха гъба, синтезираща нафта
Хари Стробъл и негови колеги от университета в Монтана (Montana State University) откриха в амазонската джунгла гъба с поразителни качества. Този вид дървесна гъба е първият жив организъм, съумял по естествен начин да синтезира автомобилното гориво - нафта.
Най-крадените автомобили за 2008-а
Организациите IIHS (Insurance Institute for Highway Safety) и HLDI (Highway Loss Data Institute) обявиха десетката на най-популярните сред автомобилните крадци модели.
Европа вече не купува нови коли
Продажбите на нови автомобили в Европа са спаднали през ноември с 25,8 процента на годишна основа, в резултат на
икономическата и финансовата криза, съобщава Асоциацията на производителите на автомобили в Европа (ACEA).
Скоростта на шофьора надига или сваля ”легналия полицай”
Нова разработка позволява на „легналия полицай” да се „прибира", ако скоростта на движещия се над него автомобил не превишава 30 км/час. Ако скоростта е по-висока, „полицаят” е в основната си позиция.
Започва градежът на новата отсечка на метрото ”Надежда”- ”Черни връх”
До началото на септември 2012 г. трябва да приключи строителството на втория диаметър на софийското метро Пътен възел: Надежда - Централна ж.п.гара - пл. св. Неделя - НДК - бул.Черни връх“.
Подобрен Nissan GT-R за Европа
Nissan обяви окончателната спецификация на европейския вариант на суперспортния автомобил GT-R.